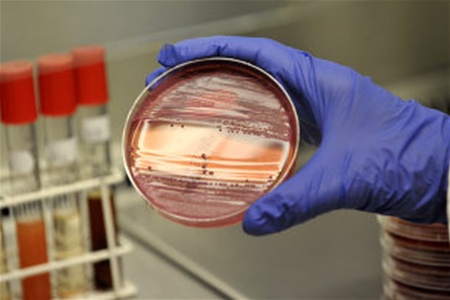
В Севастополе за неделю кишечными инфекциями заболело 60 человек В Севастополе за неделю кишечными инфекциями заболело 60 человек

В Севастополе на прошлой неделе зарегистрировано 60 случаев заболеваний острыми кишечными инфекциями. Об этом сообщила пресс-служба Санитарно-эпидемиологической службы Севастополя.
Показатель заболеваемости среди населения города зарегистрирован на уровне выше среднемноголетнего и составил 1,5 на 10 тыс. населения. В 88,3% случаев заболеваний фактором передачи инфекции послужили пищевые продукты. Заболевания острыми кишечными инфекциями связанны с употреблением пищи в домашних условиях при несоблюдении технологии приготовления или нарушении условий и сроков хранения. Зарегистрированы случаи заноса острой кишечной инфекцией в два детских сада.
